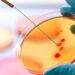
Typhoid could be latest medical risk to UK as strains build tolerance to antibiotics

Travel chaos is looming at Heathrow Airport after British Airways staff voted overwhelmingly in favour of strike action over the summer holidays. Check-in workers and ground-handling agents backed walkouts in a dispute over reinstating pandemic pay cuts.
Unions Unite and GMB say around 95% of those balloted voted in favour of the industrial action, in a move set to cause more travel chaos as the industry struggles to recover from the Covid pandemic.
Dates for strikes have yet to be announced as unions give British Airways a chance to respond. But here’s everything you need to know about what will happen and what you can do about flights already booked.
Read more: Scots castle at centre of bankruptcy battle over £230 bill goes on sale for whopping £1.25million
Why are British Airways staff going on strike?
The proposed industrial action is in response to money that was cut from workers’ pay. As flights were grounded due to coronavirus, British Airways introduced a salary sacrifice of around 10%. Unions are asking British Airways to reinstate that pay or the walk-outs will continue.
Unite officer Russ Ball said: “The problems British Airways is facing are entirely of its own making. It brutally cut jobs and pay during the pandemic even though the government was paying them to save jobs.”
British Airways bosses have reportedly offered a 10% one-off bonus payment, but have so far refused to agree to a full reinstation of the wage deduction.
Nadine Houghton, GMB Union’s national officer, added: “With grim predictability, holidaymakers face massive disruption thanks to the pig-headedness of British Airways. BA has tried to offer our members crumbs from the table in the form of a 10% one-off bonus payment, but this doesn’t cut the mustard.”
A BA statement said: “We’re extremely disappointed with the result and that the unions have chosen to take this course of action. Despite the extremely challenging environment and losses of more than £4bn, we made an offer of a 10% payment which was accepted by the majority of other colleagues.
“We are fully committed to working together to find a solution because to deliver for our customers and rebuild our business we have to work as a team. We will of course keep our customers updated about what this means for them as the situation evolves.”
How will existing holidays be affected?
British Airways, which operates from terminals three and five, has plans to cover staff, including managers potentially dealing with check-ins. However, there would still be a disruption for passengers, especially at terminal five, leading to cancellations, which would be focused on routes with several daily flights.
If you have plans to jet off somewhere warm and sunny over the school break, keep an eye on flight updates as it nears your departure date. Strikes by staff are considered within the airline’s control as it is negotiating with the workforce, as per the Denied Boarding Regulations. Airlines must also reroute passengers as soon as possible using other carriers if necessary.
Read next: